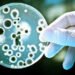
День рождения пенициллина, День позитивного мышления. Что еще можно отметить 13 сентября

Поліція вивела пару з літака компанії EasyJet. Рішення прийняли через те, що молоді люди зайнялися сексом в туалеті на борту.
Видання Independent пише, що викрив закоханих бортпровідник, передає УНІАН, інформує UAINFO.org.
При цьому перед тим, як пару викрили, чути, як інші пасажири сміються, і хтось каже збентеженому співробітнику авіакомпанії: "Давай!". Інший пасажир, який знаходився поруч, закричав: "О, Боже".
"Ми можемо підтвердити, що цей рейс з Лутона на Ібіцу 8 вересня зустріла поліція по прибуттю через поведінку двох пасажирів на борту", – повідомив представник easyJet.
Незрозуміло, чи були вжиті якісь заходи щодо закоханої пари. У Великобританії не існує закону, який би прямо регулював подібні ситуації в літаку, але згідно зі статтею 71 Закону про сексуальні злочини 2004 року навмисна участь у сексуальних діях у громадському туалеті є "злочином".
Підписуйся на сторінки UAINFO Facebook, Telegram, Twitter, YouTube